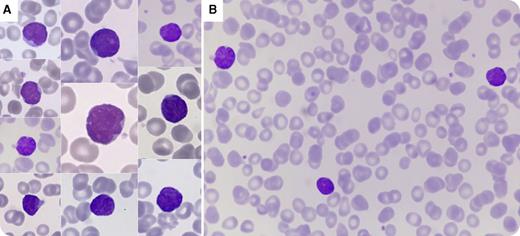
This peripheral blood smear from a 12-year-old child, cytomegalovirus and Epstein-Barr virus negative, 2 months after allogeneic stem cell transplantation (AlloSCT) for acute myeloid leukemia with maturation, shows atypical lymphocytes (panel A; for both panels, original magnification ×100, May-Grünwald Giemsa stain). Laboratory studies showed 42% homogenous atypical lymphocytes in a post-AlloSCT leukopenia (1.6 × 109/L). These cells show an irregular nuclear outline, a round nucleolus, moderately condensed chromatin, and a high nuclear-to-cytoplasmic ratio mimicking lymphoblastic cells (panel B). The forward scatter/side scatter/CD45 panel of the flow cytometric analysis shows 42% of cells located in the lymphocyte gate and no CD45low cells corresponding to blasts. Lymphocyte immunophenotyping revealed an exclusive B-lineage profile of CD19+, CD5+, CD24++, CD27−, CD38++ with polyclonal expression of surface immunoglobulin, typical of transitional B cells. / Transitional B cells are the first B-lymphoid cells detected 1.5 to 2 months after AlloSCT. The proportion of these cells, usually morphologically similar to mature B cells, gradually decreases while the mature B cells increase. This case of blast-like appearance in a young patient with AlloSCT highlights the fact that some transitional B cells can be morphologically confusing with blasts, especially when the initial diagnostic is an acute lymphoid leukemia. Flow cytometry is the best option to differentiate between those 2 immature cells.

This peripheral blood smear from a 12-year-old child, cytomegalovirus and Epstein-Barr virus negative, 2 months after allogeneic stem cell transplantation (AlloSCT) for acute myeloid leukemia with maturation, shows atypical lymphocytes (panel A; for both panels, original magnification ×100, May-Grünwald Giemsa stain). Laboratory studies showed 42% homogenous atypical lymphocytes in a post-AlloSCT leukopenia (1.6 × 109/L). These cells show an irregular nuclear outline, a round nucleolus, moderately condensed chromatin, and a high nuclear-to-cytoplasmic ratio mimicking lymphoblastic cells (panel B). The forward scatter/side scatter/CD45 panel of the flow cytometric analysis shows 42% of cells located in the lymphocyte gate and no CD45low cells corresponding to blasts. Lymphocyte immunophenotyping revealed an exclusive B-lineage profile of CD19+, CD5+, CD24++, CD27−, CD38++ with polyclonal expression of surface immunoglobulin, typical of transitional B cells.
Transitional B cells are the first B-lymphoid cells detected 1.5 to 2 months after AlloSCT. The proportion of these cells, usually morphologically similar to mature B cells, gradually decreases while the mature B cells increase. This case of blast-like appearance in a young patient with AlloSCT highlights the fact that some transitional B cells can be morphologically confusing with blasts, especially when the initial diagnostic is an acute lymphoid leukemia. Flow cytometry is the best option to differentiate between those 2 immature cells.
This peripheral blood smear from a 12-year-old child, cytomegalovirus and Epstein-Barr virus negative, 2 months after allogeneic stem cell transplantation (AlloSCT) for acute myeloid leukemia with maturation, shows atypical lymphocytes (panel A; for both panels, original magnification ×100, May-Grünwald Giemsa stain). Laboratory studies showed 42% homogenous atypical lymphocytes in a post-AlloSCT leukopenia (1.6 × 109/L). These cells show an irregular nuclear outline, a round nucleolus, moderately condensed chromatin, and a high nuclear-to-cytoplasmic ratio mimicking lymphoblastic cells (panel B). The forward scatter/side scatter/CD45 panel of the flow cytometric analysis shows 42% of cells located in the lymphocyte gate and no CD45low cells corresponding to blasts. Lymphocyte immunophenotyping revealed an exclusive B-lineage profile of CD19+, CD5+, CD24++, CD27−, CD38++ with polyclonal expression of surface immunoglobulin, typical of transitional B cells.
Transitional B cells are the first B-lymphoid cells detected 1.5 to 2 months after AlloSCT. The proportion of these cells, usually morphologically similar to mature B cells, gradually decreases while the mature B cells increase. This case of blast-like appearance in a young patient with AlloSCT highlights the fact that some transitional B cells can be morphologically confusing with blasts, especially when the initial diagnostic is an acute lymphoid leukemia. Flow cytometry is the best option to differentiate between those 2 immature cells.
For additional images, visit the ASH IMAGE BANK, a reference and teaching tool that is continually updated with new atlas and case study images. For more information visit http://imagebank.hematology.org.